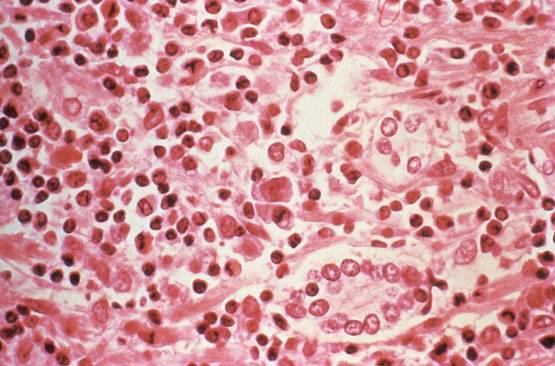
चीन: बस में हो गई थी मौत, हंता वायरस पॉजिटिव निकला शख्स

चीन: बस में हो गई थी मौत, हंता वायरस पॉजिटिव निकला शख्स
चीन के युनान प्रोविन्स के व्यक्ति की हंता वायरस से मौत हो गई है. मृत व्यक्ति एक बस में सफर कर रहा था. इसके बाद उस बस में सफर कर रहे 32 अन्य लोगों की भी जांच की गई है. एक तरफ जब दुनिया कोरोना वायरस से जूझ रही है, उसी वक्त हंता वायरस से मौत की ये खबर आई है.
हंता वायरस कोई एक वायरस नहीं होता. बल्कि कई वायरसों के समूह को इस नाम से संबोधित किया जाता है. ये वायरस आमतौर पर चूहों में पाया जाता है, लेकिन इस वायरस से चूहों को कोई नुकसान नहीं होता.
हंता वायरस दुनिया के विभिन्न हिस्सों में पहले से मौजूद है, इनमें एशिया, अफ्रीका से लेकर अमेरिका तक शामिल हैं. हंता वायरस से इंसानों को कई प्रकार की बीमारियां हो सकती हैं.
Advertisement
हंता वायरस से होने वाली बीमारियों में हल्का बुखार या फ्लू से लेकर सांस की गंभीर बीमारी भी हो सकती है. इससे लगातार खून बहने और किडनी की बीमारी भी हो सकती है.
यूरोप, एशिया और अफ्रीका में पाए जाने वाले हंता वायरस को ओल्ड वर्ल्ड हंता वायरस कहते हैं. इनसे लगातार खून बहने और किडनी की बीमारी हो सकती है.
वहीं, अमेरिका में पाए जाने वाले हंता वायरस को न्यू वर्ल्ड हंता वायरस कहा जाता है. न्यू वर्ल्ड हंता वायरस से सांस की गंभीर बीमारी हो सकती है. इसे हंता वायरस पल्मनेरी सिंड्रोम (HPS) भी कहते हैं.
Advertisement